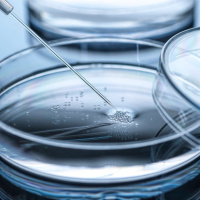
Künstliche Embryonen: Neue Wege zur Erforschung menschlicher Entwicklung

Sinopsis
SWR2 Impuls. Das Magazin für Neugierige und Wissensdurstige. SWR2 Impuls möchte täglich Denkanstöße geben mit Wissenswertem, Außergewöhnlichem und Skurrilem aus allen Bereichen des Alltags. Impuls will unterhalten mit Musik und Beiträgen, die sich wohltuend vom Mainstream abheben.
Episodios
-
Krankenhäuser: Klimamanager senken den CO2-Ausstoß
22/06/2023 Duración: 07min5% des deutschen CO2-Ausstoßes kommen aus Krankenhäusern, Arztpraxen und Rehakliniken. Damit der Gesundheitssektor klimafreundlicher wird, wurden 50 Klimamanager*innen im Auftrag des Bundesumweltministeriums ausgebildet. Was bringt das und wie arbeiten sie?
-
Gärtnern ohne Umgraben – Geht das?
22/06/2023 Duración: 05minDer englische Gartenexperte Charles Dowding beschreibt in seinem Ratgeber „No Dig – Gärtnern ohne Umgraben“ einen neuen Ansatz für den Gartenbau. Wie funktioniert das? Und was halten Gärtner*innen in Deutschland von der Methode?
-
Fangverbot: Keine Felchen mehr aus dem Bodensee
22/06/2023 Duración: 06minDer Felchen ist der beliebteste Speisefisch aus dem Bodensee. Doch sein Bestand ist aktuell stark gefährdet. Aus diesem Grund kommt jetzt ein dreijähriges Fangverbot. Was sind die Gründe für den Rückgang der Felchen und wie können die Fischer trotzdem noch Bodenseefische fangen? Christoph König im Gespräch mit Dr. Jan Baer, Fischereiforschungsstelle Baden-Württemberg in Langenargen
-
Verschiebung der Erdachse ist auch menschengemacht
22/06/2023 Duración: 02minDie Rotationsachse der Erde ist um 23,5° gegenüber der Umlaufbahn um die Sonne geneigt – Grund für die Jahreszeiten. Die Achse verschiebt sich aber – auch durch menschengemachte Prozesse.
-
In Italien und Polen predigt jetzt ein Roboter
22/06/2023 Duración: 04minEin italienischer Forscher hat einen „Roboterheiligen“ entwickelt, der Bibeltexte wiedergibt und Antworten auf religiöse Fragen liefert. SanTO soll Menschen zur Seite stehen, die keine Kirche mehr aufsuchen können. Ein Zukunftskonzept für die katholische Kirche?
-
Die SWR-Apfelblütenaktion: Eine Frühlingsbilanz
21/06/2023 Duración: 07minHeute ist kalendarischer Sommeranfang. Doch wie stand es diesen Frühling um unsere Apfelbäume? Haben sie früher oder später begonnen zu blühen? Und lässt sich eine Tendenz aus den vergangenen Jahren ablesen? Antworten liefert die SWR-Apfelblütenaktion. Christoph König im Gespräch mit Uwe Gradwohl, SWR-Wissenschaftsredaktion
-
Künstliche Embryonen: Neue Wege zur Erforschung menschlicher Entwicklung
21/06/2023 Duración: 03minÜber die embryonale Entwicklung des Menschen wissen wir erstaunlich wenig. Der Grund: Zum Schutz des ungeborenen Kindes darf kaum an Embryonen geforscht werden. Wissenschaftler*innen haben nun Fortschritte bei der Entwicklung von künstlichen Embryonen gemacht. Welche Bedeutung hat das für die Wissenschaft?
-
Erholsam schlafen – aber wie?
21/06/2023 Duración: 10minHeute ist Aktionstag des gesunden Schlafs. In Deutschland leiden viele Menschen unter Schlafstörungen. Doch was kann man tun, um besser zu schlafen? Wann werden Schlafstörungen zu einer ernstzunehmenden Krankheit? Und was bewirken Mittel wie Melatoninsprays? Christoph König im Gespräch mit Dr. Hans-Günter Weeß, Vorstandsmitglied der Deutschen Gesellschaft für Schlafforschung und Schlafmedizin
-
Neue Techniken: Wie Insekten dem Mäher entkommen können
21/06/2023 Duración: 05minBei Mäharbeiten sterben zahlreiche Insekten. Die Tiere bemerken die Gefahr in der Regel nicht rechtzeitig. Nun werden neue Mähtechniken und Hilfsmittel entwickelt, wie etwa eine Insektenscheuche, die das ändern sollen.
-
Kommentar: Entschärfung des Klimaschutzgesetzes
21/06/2023 Duración: 03minKlimaschutzgesetz: bf5b32bb-1f3f-4b71-998e-5125c28dd9d5 Umwelt Heute berät das Bundeskabinett über grundlegende Änderungen des Klimaschutzgesetzes. Strengere jährliche Ziele für die Bereiche Energie, Industrie, Verkehr, Gebäude, Landwirtschaft und Abfallwirtschaft sollen wieder abgeschafft werden. Umweltverbände kritisieren das Vorgehen stark.
-
Verkehrskongress: Mehr Leute aufs Rad – aber wie?
20/06/2023 Duración: 07minViele Fragen beschäftigen Forschende auf dem nationalen Radverkehrskongress: Wie kann das Radverkehrsnetz schnell verbessert werden? Welche politischen Rahmenbedingungen müssen dafür geschaffen werden? Und warum klappt das in den Niederlanden so viel besser? Christoph König im Gespräch mit Prof. Jochen Eckart, Verkehrsökologe Hochschule Karlsruhe
-
Gewittermythen: Nicht duschen, nicht telefonieren - oder doch?
20/06/2023 Duración: 02minDarf man während eines Gewitters wirklich nicht duschen und auch nicht telefonieren? Viele Verhaltensregeln haben sich in unseren Köpfen eingebrannt. Doch welche stimmen? Und welche sind überholt?
-
Pustefix: 75 Jahre Seifenblasen aus Flaschen
20/06/2023 Duración: 05min1948 begann die Erfolgsgeschichte des Seifenblasenröhrchens. Die Hersteller-Firma hat bis heute ihren Sitz in Tübingen und exportiert in die ganze Welt. Aber das Rezept für die perfekte Seifenblase ist nach wie vor streng geheim.
-
Reform der Kliniken in Deutschland: Was ist sinnvoll?
20/06/2023 Duración: 04minBeim bundesweiten Aktionstag machen Kliniken auf ihre Probleme aufmerksam und fordern schnelle Hilfen. Derweil plant Bundesgesundheitsminister Karl Lauterbach die Neustrukturierung der Krankenhäuser. Was sagen Experten? Passt das Vorhaben zu den Forderungen der Krankenhäuser?
-
Kommentar: Was bringt das UNO-Hochseeabkommen?
20/06/2023 Duración: 03minEin Abkommen, das sogar von Umweltverbänden gelobt wird: Nach jahrelangen Verhandlungen wurde gestern das erste internationale Hochseeabkommen verabschiedet. Mehr als 60 Prozent der Meeresgebiete sollen zu Schutzgebieten werden. Das Abkommen enthält noch viele weitere, gute Details.
-
Mainzer Uniklinik behandelt zwei geflüchtete Iraner
20/06/2023 Duración: 03minSie wurden von Revolutionsgarden des iranischen Regimes angeschossen. Mit viel Glück haben die beiden jungen Iraner überlebt. Eine Hilfsorganisation hat sie nach Deutschland geholt. Jetzt werden die beiden Flüchtlinge in Mainz behandelt.
-
In Frankreich boomt der Kunstrasen
19/06/2023 Duración: 03minParis wie Marseille und Marseille wie Algier – das sind Klimaprognosen für die nahe Zukunft. Auch 2023 wird ein extrem trockenes Jahr für Frankreich: Schon jetzt brennen Wälder und es mangelt an Grundwasser. Gartenbesitzer*innen bereiten sich auf ihre eigene Art auf den Dürresommer vor – mit künstlichem Rasen.
-
Rumänien startet Jagd auf Bären
19/06/2023 Duración: 04minRund 8000 wilde Braunbären gibt es in Rumänien – und ihre Zahl und die Angriffe auf Menschen nehmen stetig zu. Deshalb hat die rumänische Regierung nun knapp 500 Bären zum Abschuss freigegeben - ein umstrittener Erlass.
-
Die Schweiz stimmt für mehr Klimaschutz
19/06/2023 Duración: 03minIn einem Referendum haben sich rund 58 Prozent der Schweizer*innen für ein neues Klimaschutzgesetz ausgesprochen. Durch eine Vielzahl an Maßnahmen soll die Schweiz bis 2050 CO2-neutral werden.
-
Deutschlandfinale: Roboter-Olympiade in Freiburg
19/06/2023 Duración: 06min122 Teams haben sich für das Deutschlandfinale der „World Robot Olympiad“ qualifiziert. In Kategorien wie „Robosports“ und „Future Innovations“ traten sie am vergangenen Wochenende gegeneinander an. In der Messehalle gab es unter anderem Roboter-Tennisspiele und einen autonomen Müllsammel-Roboter.